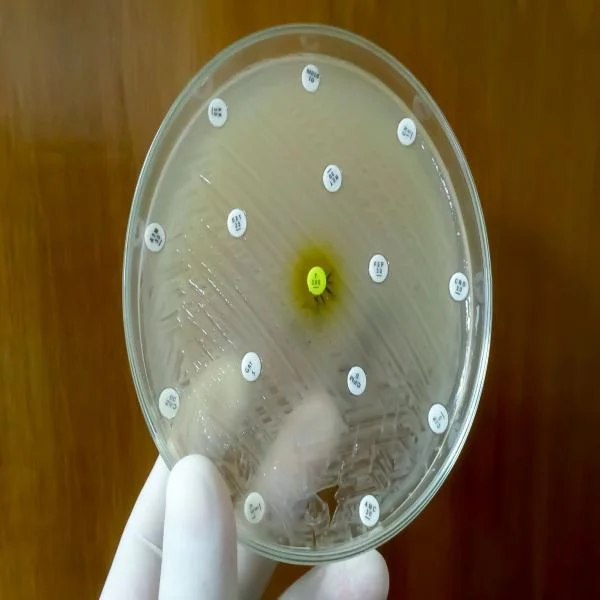
Biết Kháng Sinh Gây Hại: Tại Sao Người Nuôi Vẫn Không Đều Lạm Dụng?

Bệnh Tật Ở Tôm Giống: Nhận Diện Sớm Để Bảo Vệ Đàn Tôm
Ngành nuôi tôm đã trở thành một trong những lĩnh vực nông nghiệp quan trọng, góp phần không nhỏ vào nền kinh tế của nhiều quốc gia, đặc biệt là các nước ven biển. Trong quá trình nuôi, giai đoạn ấu trùng và giống tôm là giai đoạn cực kỳ nhạy cảm và dễ bị ảnh hưởng bởi bệnh tật. Những bệnh này không chỉ gây thiệt hại về kinh tế mà còn ảnh hưởng đến chất lượng sản phẩm và sức khỏe của người tiêu dùng. Bài viết này sẽ đi sâu vào một số bệnh phổ biến trên tôm ở giai đoạn ấu trùng và giống, nguyên nhân, triệu chứng, phương thức lây lan và các biện pháp phòng ngừa.
Các bệnh thường gặp trên tôm ở giai đoạn ấu trùng và giống
Bệnh nhiễm vi khuẩn
Bệnh hoại tử gan tụy cấp tính (AHPND)
AHPND là một trong những bệnh nghiêm trọng nhất ảnh hưởng đến tôm nuôi, đặc biệt là tôm thẻ chân trắng. Bệnh này gây ra bởi vi khuẩn Vibrio parahaemolyticus có tính độc lực cao.
Triệu chứng:
- Tôm thường xuyên có biểu hiện giảm ăn, bơi lội yếu ớt.
- Xuất hiện các triệu chứng hoại tử ở gan và tụy, dẫn đến tỷ lệ chết cao.
Phòng ngừa:
- Đảm bảo vệ sinh ao nuôi, khử trùng định kỳ.
- Sử dụng giống tôm khỏe mạnh, đã được kiểm tra sức khỏe.
Bệnh vi khuẩn đỏ (Red Disease)
Bệnh này do vi khuẩn Vibrio spp. gây ra và thường xuất hiện ở tôm ở mọi giai đoạn phát triển.
Triệu chứng:
- Xuất hiện màu đỏ trên cơ thể tôm, đặc biệt ở vùng mang và chân.
- Tôm bơi lờ đờ, không còn linh hoạt.
Phòng ngừa:
- Cải thiện chất lượng nước và chế độ dinh dưỡng.
- Thực hiện các biện pháp vệ sinh và khử trùng ao nuôi.
Bệnh nhiễm virus
Bệnh Virus Đục Mắt (IHHNV)
IHHNV (Infectious Hypodermal and Hematopoietic Necrosis Virus) là một loại virus có thể gây bệnh nghiêm trọng cho tôm ấu trùng.
Triệu chứng:
- Tôm có biểu hiện mắt bị đục, màu sắc cơ thể nhợt nhạt.
- Tôm có thể chết đột ngột mà không có dấu hiệu trước đó.
Phòng ngừa:
- Sử dụng giống tôm đã được kiểm tra virus.
- Đảm bảo vệ sinh ao nuôi và các thiết bị liên quan.
Bệnh DIV1 (Disease of Infectious Vannamei 1)
Bệnh DIV1 do virus DIV1 gây ra, có khả năng lây lan nhanh chóng và gây thiệt hại lớn.
Triệu chứng:
- Tôm có dấu hiệu giảm ăn, màu sắc cơ thể nhợt nhạt.
- Tử vong đột ngột mà không có triệu chứng rõ ràng.
Phòng ngừa:
- Thực hiện kiểm tra sức khỏe định kỳ cho tôm.
- Đảm bảo chất lượng nước và vệ sinh ao nuôi.
Bệnh nấm
Bệnh nấm trắng (Saprolegnia)
Nấm trắng là một trong những bệnh nấm phổ biến nhất ở tôm, thường xuất hiện trong điều kiện nước ô nhiễm hoặc môi trường nuôi kém.
Triệu chứng:
- Xuất hiện các mảng trắng trên cơ thể tôm, đặc biệt là ở vùng mang và chân.
- Tôm bơi lội kém và có dấu hiệu suy giảm sức khỏe.
Phòng ngừa:
- Duy trì chất lượng nước tốt và tránh ô nhiễm.
- Cải thiện thông gió trong ao nuôi để giảm độ ẩm.
Nguyên nhân gây bệnh
Chất lượng nước
Chất lượng nước là yếu tố quan trọng quyết định đến sức khỏe tôm. Nước ô nhiễm, nồng độ oxy thấp, pH không ổn định sẽ tạo điều kiện thuận lợi cho sự phát triển của mầm bệnh.
Chế độ dinh dưỡng
Chế độ dinh dưỡng không đầy đủ sẽ làm giảm sức đề kháng của tôm, khiến chúng dễ bị nhiễm bệnh. Việc cung cấp thức ăn không sạch sẽ hoặc có chất lượng kém cũng có thể gây hại cho tôm.
Mật độ nuôi
Mật độ nuôi quá cao sẽ dẫn đến sự cạnh tranh giữa các cá thể, gia tăng stress và dễ dàng lây lan bệnh tật.
Triệu chứng chung của bệnh trên tôm ấu trùng và giống
- Giảm ăn: Tôm thường xuyên có biểu hiện từ chối thức ăn.
- Suy giảm sức khỏe: Bơi lội yếu, không còn linh hoạt, dễ bị tổn thương.
- Thay đổi màu sắc: Màu sắc cơ thể tôm nhợt nhạt hoặc có đốm nâu, đỏ.
- Tử vong đột ngột: Một số trường hợp không có triệu chứng rõ ràng trước khi chết.
Các biện pháp phòng ngừa và kiểm soát bệnh
Quản lý chất lượng nước
- Kiểm tra định kỳ: Theo dõi các chỉ số chất lượng nước như pH, nhiệt độ, nồng độ oxy, amoniac, nitrit, nitrat và vi khuẩn.
- Thay nước định kỳ: Giúp cải thiện chất lượng nước và giảm thiểu mầm bệnh.
Sử dụng giống tôm an toàn
- Kiểm tra sức khỏe giống tôm: Chọn giống đã được kiểm tra và không nhiễm bệnh.
- Nguồn giống chất lượng: Đảm bảo nguồn giống từ các cơ sở uy tín, có giấy chứng nhận an toàn.
Chế độ dinh dưỡng hợp lý
- Cung cấp thức ăn chất lượng: Đảm bảo thức ăn sạch sẽ, giàu dinh dưỡng và phù hợp với từng giai đoạn phát triển của tôm.
- Bổ sung vitamin và khoáng chất: Giúp tăng cường sức đề kháng cho tôm.
Vệ sinh môi trường nuôi
- Khử trùng ao nuôi: Thực hiện khử trùng ao nuôi định kỳ để loại bỏ mầm bệnh.
- Quản lý thiết bị nuôi: Vệ sinh và khử trùng các thiết bị, dụng cụ trước và sau khi sử dụng.
Theo dõi sức khỏe tôm
- Kiểm tra sức khỏe định kỳ: Phát hiện sớm các triệu chứng bệnh để có biện pháp xử lý kịp thời.
- Quản lý mật độ nuôi: Giảm mật độ nuôi để hạn chế sự lây lan của bệnh.
Điều trị bệnh
Sử dụng thuốc kháng sinh
- Kháng sinh: Sử dụng kháng sinh phù hợp với từng loại bệnh, nhưng cần thận trọng để tránh kháng thuốc.
- Chế phẩm sinh học: Sử dụng chế phẩm sinh học để cải thiện hệ vi sinh vật trong ao nuôi.
Biện pháp hỗ trợ
- Bổ sung khoáng chất: Giúp tăng cường sức đề kháng cho tôm.
- Thay nước thường xuyên: Cải thiện chất lượng nước và giảm mầm bệnh.
Giai đoạn ấu trùng và giống tôm là thời điểm rất nhạy cảm và dễ bị ảnh hưởng bởi nhiều loại bệnh tật. Việc hiểu rõ các bệnh thường gặp, nguyên nhân và triệu chứng sẽ giúp người nuôi có những biện pháp phòng ngừa và điều trị hiệu quả, bảo vệ đàn tôm và duy trì năng suất nuôi trồng.
Để đảm bảo sự phát triển bền vững của ngành nuôi tôm, cần phải chú trọng vào việc nâng cao chất lượng giống, cải thiện môi trường nuôi và thực hiện các biện pháp quản lý phù hợp. Thông qua việc tăng cường kiến thức và ý thức trong cộng đồng nuôi tôm, chúng ta có thể giảm thiểu nguy cơ bệnh tật và hướng tới một ngành nuôi tôm phát triển ổn định và bền vững.